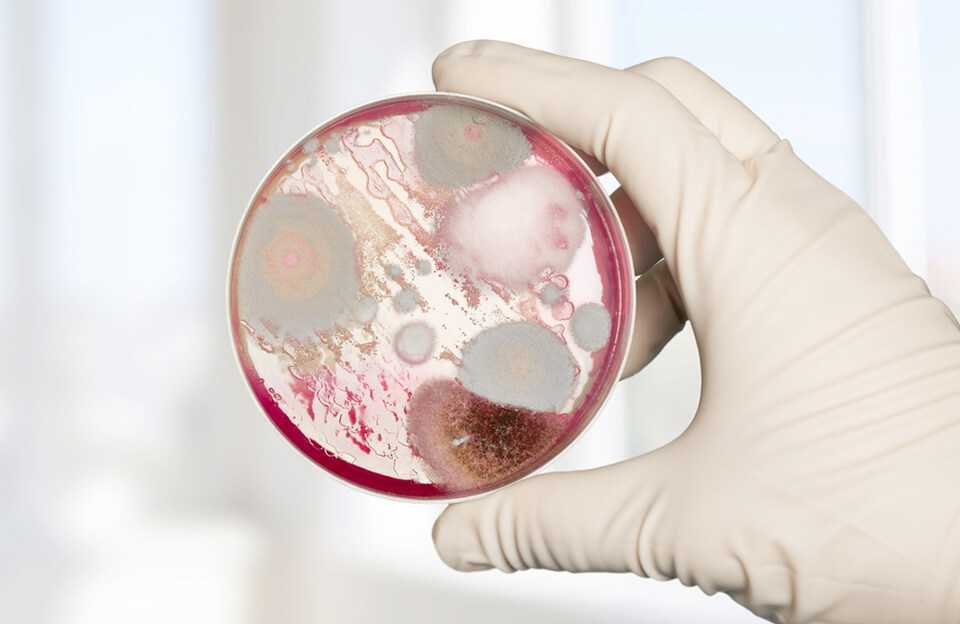

Причины
- Предшествующая аномалия эндокарда
- Присутствие микроорганизмов в кровотоке (бактериемия)
Микроорганизмы
Практически любой чужеродный имплантированный материал (например, желудочковый или перитонеальный шунт, протез) подвергается риску бактериальной колонизации, тем самым становясь источником бактериемии и, следовательно, эндокардита.
- Бактериемия: микроорганизмы присутствуют в крови
- Адгезия: микроорганизм присоединяется к аномальному или поврежденному эндотелию с помощью поверхностных адгезинов
- Колонизация: пролиферация организма вместе с развитием воспаления, что приводит к образованию зрелых вегетаций
Кахектический эндокардит
- скрытые очаги дремлющей инфекции различной локализации: тонзиллиты, кариозные зубы;
- врождённые и приобретённые пороки сердца, наследственные аномалии его развития;
- первичный и вторичный иммунодефицит;
- стресс, вялотекущие хронические заболевания, вызывающие ослабление защитных сил организма;
- наркомания;
- пожилой возраст.
Признаки и методики диагностики ИЭ
Септический эндокардит начинается остро. Внезапно до 39-40 С поднимается температура тела, возникает сильный озноб, боль в мышцах и суставах. Слизистые оболочки и кожа бледнеют, на ней появляются мелкие высыпания (геморрагическая сыпь), присутствуют узелковые высыпания на подошвах стоп и ладонях малинового оттенка (узелки Оспера), исчезающие через несколько дней после начала заболевания. Если присоединяется инфекция, то высыпания нагнаиваются, а в дальнейшем происходит их рубцевание. К ногтевым фалангам утолщаются пальцы верхних и нижних конечностей, они принимают характерный вид, известный, как «барабанные палочки», а ногти – «часовые стекла». Могут быть кровоизлияния под ногтями в форме полосок красновато-коричневого цвета.
При выслушивании сердечных тонов четко определяются посторонние шумы, имеющие разные тона и громкость, в зависимости от степени поражения клапанов, часто одновременно диагностируется миокардит, аритмия, сердечная недостаточность.
Это классические признаки эндокардита, но иногда они видоизменяются или частично отсутствуют. Для уточнения диагноза нужно выявить наличие в крови патогенного микроорганизма, для чего лабораторными методами исследуют артериальную кровь. Вегетации микроорганизмов на сердечном клапане можно обнаружить с помощью эхокардиограммы – УЗИ сердца. Нередко на начальной стадии болезни эндокардит не удается распознать, поскольку такие или аналогичные симптомы могут сопровождать и другие острые инфекционные болезни.

рисунок: признаки и осложнения эндокардита
При подозрении на ИЭ врач должен оценивать все признаки болезни в совокупности. Если первый посев крови не дал положительный результат, его осуществляют повторно, неоднократно. Также при подозрении на это заболевание необходимо назначение ЭхоКГ, поскольку это является наиболее информативным методом, позволяющим обнаружить и визуализировать патологии сердечного клапана и разрастания микроорганизмов. В процессе проведения лечения с помощью ЭхоКГ проводят контроль эффективности проводимой терапии. В отдельных случаях по показаниям проводят диагностическую биопсию эндокарда для того, чтобы подтвердить диагноз.
- Биохимический и общий анализ крови подтверждают протекающий воспалительный процесс в организме;
- Рентгенография грудной клетки определяет изменения в легких при эмболии легочной артерии;
- УЗИ сердца позволяет визуально определить наличие ИЭ и детально его описать.
Видео: инфекционный эндокардит на ЭхоКГ
В ролике: инфекционный эндокардит трикуспидального клапана, вегетация. Эхокардиография, верхушечный доступ.
Диагностика инфекционного эндокардита
Изменения лабораторных показателей:
1. анемия;
2. сдвиг лейкоцитарной формулы влево при нормальном (чаще) или уменьшенном количестве лейкоцитов;
3. тромбоцитопения;
4. резко увеличенная СОЭ;
5. гипопротеинемия, гипергаммаглобулинемия, появление С- реактивного белка;
6. положительный ревматоидный фактор, высокий уровень цир-кулирующих иммунных комплексов, антинуклеарный фактор в низких титрах;
7. протеинурия, гематурия.
Любой пациент с подозрением на клапанный эндокардит должен быть направлен на ЭхоКГ-исследование. Разрешающая диагностическая способность трансторакальной двухмерной ЭхоКГ с использованием допплеровской техники при ИЭ составляет 80%. Применение чреспищеводной ЭхоКГ повышает чувствительность данного метода для диагностики ИЭ до 90–94%. Чреспищеводная ЭхоКГ проводится в случаях, если:
1. клинически вероятность ИЭ высокая, а стандартная ЭхоКГ негативна;
2. при подозрении на ИЭ протеза клапана;
3. при положительной трансторакальной ЭхоКГ и подозрении на повреждения клапанов, а также перед операцией при остром ИЭ.
В случае высокой вероятности ИЭ по клиническим данным и нормальной чреспищеводной ЭхоКГ,
рекомендуется повторить обследование через неделю. Негативный результат при повторном
обследовании фактически исключает диагноз ИЭ. В случае, если на изображении хорошего качества
изменений нет, а клинические признаки неубедительны, то наличие ИЭ маловероятно.
В этом случае рекомендуется искать другие причины заболевания.
Инфекционный артрит: причины, механизм, осложнения
Что такое инфекционный артрит? Инфекционный артрит — это острое или хроническое воспаление, которое возникает в суставной сумке вследствие бактериального или вирусного заражения. Инфекция (гонококковая или негонококковая) может развиваться в синовиальной оболочке, синовиальной жидкости и прилегающих к суставу мягких тканях. Инкубационный период, как правило, варьируется от нескольких часов до нескольких дней (обычно не больше 10).
Многие патогенные микроорганизмы вырабатывают т.н. адгезивные белки и кислоты, которые помогают им закрепиться на суставных поверхностях для дальнейшего размножения. Эти вещества фактически “разъедают” хрящ — начальная эрозия перерастает в необратимые изменения по мере того, как микроорганизмов становится больше. Помимо плохого питания сустав страдает от ферментов, при помощи которых организм человека пытается справиться с бактериальными агентами — “растворяя” чужеродные клетки, эти белки повреждают синовиальную жидкость, связки и сам хрящ.
Каковы причины заболевания? Причиной заболевания у детей и взрослых выступают грамотрицательные и грамположительные бактерии — стафилококки, стрептококки, гонококки, ВИЧ, парвовирусы, спирохета. Заболевание краснухой, свинкой, гепатитом, дизентерией, бруцеллезом, бореллиозом может спровоцировать заражение сустава и острую форму артрита. Туберкулез, микоз и ряд других болезней часто влечет хроническую, вялотекущую форму.
Особенно подвержены болезни лица с ревматоидным и другими видами артрита и артроза, подагрой, суставными протезами, люди старше 60 лет, а также зависимые от инъекционных наркотиков или алкоголя. К факторам риска также относятся недавно перенесенные операции, иммуноподавляющая терапия, кожные инфекции, наличие бактерий в крови (бактериемия), наличие хронических заболеваний легких, печени, почек (особенно при потребности в гемодиализе), рак, сахарный диабет, венерические заболевания и ряд системных болезней.
Какие осложнения бывают при инфекционном артрите? Почти четверть пациентов, пострадавших от инфекционного артрита, жалуется на частичное или полное ограничение подвижности в пораженных суставах.
Оставленное без лечения, это заболевание может спровоцировать гнойный и даже некротический процесс в кости, прилегающих мягких тканях. Если септический процесс перебрасывается на костный мозг, может развиться воспаление позвоночного столба. Это чревато разрушением позвонков. Сравнительно высокий процент летального исхода при инфекционном артрите объясняется сильной интоксикацией организма, септическим шоком и возможным развитием дыхательной недостаточности.
1.Общие сведения
Эндокард – соединительнотканная оболочка (содержащая эластичные волокна и гладкомышечные клетки), которая выстилает внутренние поверхности сердца. По своему составу и строению эта оболочка соответствует сосудистым стенкам, а сердечные клапаны представляют собой, по сути, складки эндокарда.
Далее, эндокардит – общее название воспалительных процессов во внутренней оболочке и клапанах сердца. Такие воспаления могут развиваться под действием различных факторов, но чаще всего причиной выступает инфекция, инвазия патогенных микроорганизмов (бактерий, вирусов, грибков, простейших).
Кандидозами называют системные инфекции грибкового происхождения (микозы), вызываемые активностью условно-патогенных дрожжевых грибов рода Кандида. Лишь несколько из почти 200 видов Кандида могут быть опасными для человека, – в частности, широко известная «молочница» Candida albicans.
Таким образом, кандидозный эндокардит – инфекционно-воспалительный процесс во внутренней оболочке сердца, при определенных условиях вызываемый грибками рода Кандида.
Кандидозный эндокардит представляет собой редкую, но всегда серьезную проблему в кардиологии; это заболевание чревато тяжелыми осложнениями, является сложным в диагностике (более чем в половине случаев оно диагностируется посмертно) и характеризуется летальностью на уровне 2,3-2,4%.
Симптомы заболевания горла
Заболевание, характеризуется острым началом лихорадки (до 39,0 C), тяжелой болью в горле, особенно при глотании. При осмотре горла можно увидеть миндалины, ярко-красного цвета, возможно, наличие пустул. Болезнь характеризуется общими симптомами отравления слабость, потливость, боли в суставах, рвота, снижение аппетита. В этой форме болезнь горла может быть заразной для других, так как золотистый стафилококк выделяется из организма с выдыхаемым воздухом.
Прямое заражение происходит через дыхательные пути человека, уже инфицированного, когда капельки слюны или слизи, которые вылетают через чихание или кашель. Непрямое инфицирование: в этом случае золотистый стафилококк входит в контакт с нами через немытые руки или когда мы потребляем зараженную пищу.
Хронический тонзиллит.
В зависимости от развития болезни, это может быть:
- первичный хронический тонзиллит и
- вторичный хронический тонзиллит как следствие недопечённой болезни и развитие у золотистого стафилококка сопротивления к антибиотикам.
Симптомы идентичны в обеих формах хронического тонзиллита, вызванного золотистым стафилококком. Типичные симптомы являются локальными — боль в горле при глотании, ощущение комка в горле, миндалины красные без гнойного налета.
Фарингит.
Заболевание, которое характеризуется симптомами хронической интоксикации. Среди местных симптомов боль в горле, покраснение задней стенки горла, с отеком слизистых оболочек. Редко присутствуют гнойные налеты в задней части горла.
Комбинированный тонзиллофарингит
Эта болезнь является результатом распространения бактерий во всей полости рта. В то же время присутствуют местные симптомы — боль в горле при глотании, опухшие гланды, покраснение на задней стенке горла.
Диагностика эндокардита
Перед осмотром врач расспрашивает об операциях на сердце, возможных врожденных пороках. Во время осмотра можно определить повышенную температуру тела, увидеть узелки или шишки в области суставов, кровоизлияния. При прослушивании тонов сердца специалист дифференцирует посторонние шумы, они возникают из-за нарушений тока крови между полостями сердца.
Анализ крови при эндокардите
- Посев крови на питательные среды для определения в ней бактерий или грибков.
- Клинический анализ крови, в котором можно выявить увеличение скорости оседания эритроцитов (СОЭ). Это неспецифический маркер воспаления.
- Определение уровня С-реактивного белка (СРБ), также маркёра воспалительного процесса в организме.
90% пациентов с эндокардитом имеют повышение СРБ или СОЭ.
Культура энтерококка в чашке Петри. Shutterstock: Billion Photos.
Эхокардиография
Для исследования полостей, клапанов и мышцы сердца используют ультразвук. Это позволяет определить структурные или функциональные изменения в сердце. Также на Эхо-КГ можно увидеть вегетации в области клапанов — скопления бактерий вместе с клетками крови, фибрином. Исследование выполняют несколькими способами:
- трансторакальным — размещают датчик непосредственно на коже груди;
- чрезпищеводным — проводят зонд через рот в пищевод. Это более точный метод, так как пищевод находится непосредственно позади сердца.
Компьютерная томография
Используют рентгеновские лучи для получения множества снимков, которые потом компьютер сводит воедино. Метод важен для выявления абсцессов (ограниченных гнойников), возникающих при эндокардите в разных областях тела.
Диагностика
Чтобы подтвердить или опровергнуть инфекционный эндокардит, диагностика заболевания должна быть комплексной. Первым этапом является общий осмотр. Внешне специалист может определить:
- состояние и цвет кожных покровов;
- характер потери массы;
- изменения концевых фаланг пальцев;
- наличие петехиальных высыпаний;
- внешние проявления нарушений функции миокарда;
- нарушение сознания, параличи и иные проявления иммунных поражений, тромбоэмболий и наличия септических очагов.
Также в рамках внешнего осмотра проводится пальпация, перкуссия и аускультация сердца. При вероятном диагнозе инфекционный эндокардит симптомы бывают разными, и подтвердить или исключить патологию помогают дальнейшие обследования. Но физикальные методы позволяют определить:
- локализацию инфекционного поражения;
- сопутствующие патологии, связанные с ИЭ;
- признаки формирующегося порока полого органа и др.
Большую информативную ценность представляют результаты лабораторных исследований. По общему анализу крови врач определяет:
- лейкоцитоз;
- нормохромную анемию;
- повышенную СОЭ.
Примерно у половины больных в анализах повышен ревматоидный фактор. В частности присутствует положительный С-реактивный белок и обнаруживается гипергаммаглобулинемия.
По анализу мочи определяют небольшое содержание крови, которое не меняет ее цвет и рассматривается только под микроскопом, а также наличие белка. Биохимия крови необходима для обнаружения патологического снижения уровня альбумина в сыворотке, повышенного содержания азотистых продуктов обмена и повышения уровня креатинина. Еще одно обязательное исследование – коагулограмма.
Определить инфекционный эндокардит, причины его развития, характеристики течения и прогнозы помогает инструментальная диагностика. Список обязательных процедур возглавляет эхокардиограмма. Она незаменима для:
- составления прогноза при ИЭ;
- оценки динамики и эффективности лечения;
- оценки результата хирургического вмешательства;
- расчета риска эмболии и др.
Отличным решением для диагностики станет чреспищеводная ЭхоКГ. Проводиться она может, как до, так и во время оперативного вмешательства.
Кроме ЭхоКГ инструментальное обследование может включать мультиспиральную компьютерную, магнитно-резонансную и позитронэмиссионную томографию, а также другие варианты, позволяющие оценить состояние и функции исследуемых зон.
Лечение стрептококка
Для того чтобы предотвратить возникновение всех этих страшных заболеваний, следует уничтожить их возбудитель – стрептококк.
Лечение стрептококка осуществляется, как медикаментозно (с помощью антибиотиков и процедуры цеппинга), так и профилактически.
Лечение стрептококков может назначить только врач. Для выявления стрептококка необходимо сдать анализ мазка из горла.
Также не помешает прием и иммуномодулирующих средств, которые обладают и мочегонными свойствами. Вот небольшой список иммуномодулирующих средств для лечения и профилактики стрептококковых инфекций:
- малина;
- морковь;
- хмель (настой из шишек);
- лук огородный;
- чеснок;
- череда;
- эхинацея пурпурная;
- вишневый сок;
- клубника;
- репейник (настойка на водке);
- тысячелистник;
- орех грецкий.
Золотистый стафилококк у детей
Заражение золотистого стафилококка маленькими детьми может происходить уже в роддоме. Признаки у детей такие же, как и симптомы у взрослых.
Организм у ребенка может справиться с этой инфекцией, даже без применения медикаментов, происходит это благодаря материнскому молоку. Молоко матери усиливает защитные свойства организма.
Если ребенок родился преждевременно, имеет патологии в развитии, то защитные свойства у него ослаблены. В таком случае инфекция может приводить к серьезным повреждениям кожи, которые очень похожи на ожоги.
Также у ребенка возможно возникновение стафилококкового энтероколита. Необходимо срочно обратиться к врачу и пройти курс лечения.
Каков прогноз при эндокардите?
До недавнего времени, пока в практику не была введена терапия антибиотиками и химиопрепаратами, прогноз при этом заболевании был крайне неблагоприятным, отмечался высокий процент смертности среди больных, а случаи выздоровления были единичными. В настоящее время прогноз зависит от многих сопутствующих факторов.
Независимо от тяжести перенесенного заболевания, эндокардит в большинстве случаев оказывает влияние на всю дальнейшую жизнь человека, поскольку в дальнейшем постоянно будет иметь место риск развития порока сердечного клапана и сопутствующих осложнений. К ним относится развитие миокардита – воспаления среднего слоя сердечной мышцы, которое несет еще более тяжелые последствия, поскольку может вести к развитию кардиомиопатии, быстрому развитию сердечной недостаточности и нарушению ритма сердца. Это состояние может потребовать дополнительной симптоматической терапии. Большую опасность представляет почечная недостаточность и возникающая при этом интоксикация организма.
Диагностика
Главной задачей диагностики является выявление возбудителя инфекции, «виновного» в развитии инфекционного артрита. Обязательно также устанавливается степень разрушения сустава. Проводятся следующие исследования:
- Лабораторные:
- общий анализ крови – признаки воспаления; при токсико-аллергических формах артритов – повышенное содержание эозинофилов;
- биохимия крови – общие нарушения, свойственные той или иной инфекции;
- исследование синовиальной жидкости – характер воспаления;
- иммунологические исследования – антитела к различным возбудителям инфекции;
- ПЦР и микробиологические исследования (посев биологических сред на питательные среды) – выявление возбудителей инфекции;
- гистологические исследования – под микроскопом рассматривается кусочек ткани синовиальной оболочки, взятой методом биопсии – выявление изменений, характерных для определенной инфекции.
- Инструментальные:
- УЗИ – выявляет наличие экссудата в суставной полости и поражение мягких тканей;
- рентгенография – выявляет степень поражения костной ткани суставов;
- компьютерная томография (КТ) – детализация костных деструкций;
- диагностическая артроскопия – исследование состояния внутренней поверхности синовиальной оболочки с возможностью взятия экссудата или кусочка ткани на исследование.
Лечение инфекций горла, вызванных золотистым стафилококком
Основной терапевтический подход является комплексным, направленным на уничтожение возбудителя на слизистой оболочке горла и устранение факторов, которые способствуют переходу золотистого стафилококка к патогенной форме. Для этого применяется:
- причинное лечение,
- патогенетическая терапия,
- иммунотерапия,
- Лечение, направленное на полное уничтожение золотистого стафилококка в горле, достигается применением антибиотиков.
- Рекомендуемые антибиотики для борьбы с золотистым стафилококком;
- группа производных пенициллина, защищенных от клавулановой кислоты (амоксиклав),
- цефалоспорины (цефодокс, цефтриаксон).
Важно выдержать продолжительность лечения, пока не исчезнут все симптомы. Если лечение антибиотиками остановить, оставшиеся микроорганизмы могут выработать устойчивость к антибиотикам, что приводит к переходу в хроническую форму заболевания
При хроническом тонзиллите, развитии резистентности к антибиотикам у золотистого стафилококка. Единственный метод для уничтожения возбудителя является использование бактериофага вируса, который разрушает клетки бактерий.
Патогенетическая терапия.
Используется для снятия интоксикации. При тяжелой интоксикации дезинтоксикационная терапия проводится в виде внутривенных капельниц с солевыми растворами.
Иммунотерапия.
Это лечение для укрепления местного и общего иммунитета. Для этой цели используется группа препаратов-иммуномодуляторов (настойка эхинацеи, лимонника обыкновенного, элеутерококка). Для укрепления иммунитета также нужна нормальная диета с адекватным потреблением витаминов, устранение стресса, нормализации сна.
Для профилактики заболеваний горла, необходимо вести здоровый образ жизни, мы не должны забывать, что недостаток сна, стрессы, подрывают иммунную систему человека. Он слабеет, становится уязвимым к патогенной флоре.
Токсические стафилококковые инфекции
Золотистый стафилококк производит много токсинов, которые ответственны за определенные заболевания.
- Токсический шок. Вызван токсическим стафилококковым токсином (Токсический шок стафилококкового токсина – ЦСТ). Первоначально считалось, что стафилококковый токсический шок поражает только женщин, использующих вагинальные тампоны. Однако оказалось, что это может происходить во всех возрастных группах, включая мужчин. Токсический шок является серьезным, угрожающим жизни состоянием, характеризующимся высокой температурой, снижением артериального давления, нарушением работы органов и диффузными поражениями кожи, отслаивающимися через 1-2 недели. Кроме того, наблюдаются боли в мышцах, рвота и диарея. Токсический шок также может развиться у людей, колонизированных токсинобразующим штаммом.
- Синдром обожженной кожи (SSSS) – болезнь Риттера и Лайелла. Включает кожные заболевания различной степени тяжести, вызванные токсинами, называемыми эксфолиантами. Заболевание чаще всего встречается у новорожденных и младенцев в возрасте до 3 месяцев, очень редко у взрослых. Токсины вызывают появление тонкостенных пузырьков, которые легко лопаются, а также отслаивание эпидермиса, что приводит к обнажению дермы. Клинические симптомы в первую очередь: лихорадка, раздражительность, отсутствие аппетита, легкая сыпь, покрывающая всю поверхность тела в течение нескольких дней. Диагноз основывается на клинических симптомах, в том числе положительный кожный симптом Никольского.
- Энтеротоксины. Ответственны за пищевое отравление. Пищевое отравление происходит в результате потребления пищи, в которой пролиферируют и выделяют энтеротоксины стафилококки. Механизм действия энтеротоксинов до конца не изучен. Предполагается, что рвота является результатом активации рвотного центра спинного мозга в головном мозге, а не местного воздействия на слизистую оболочку желудочно-кишечного тракта. Тошнота и рвота начинаются через 2–6 часов после инфицирования. Затем появляются боли в животе и диарея.
Высокая температура при токсическом шоке
Факторы, которые провоцируют заболевание
К сожалению, шанс избежать возникновения золотистого стафилококка, нет ни у одного человека. Проблема заключается еще и в том, что микроорганизмы способны вырабатывать особенный фермент, который называется коагулаза. Именно он помогает защищать стафилококк от естественной защиты организма.
Существует несколько факторов, которые в разы увеличивает шанс заразиться золотистым стафилококком:
- употребление наркотиков при помощи инъекции;
- наличие хронических заболеваний, в том числе сахарный диабет, нарушение кровообращения;
- ослабление иммунитета у маленьких детей и у взрослых в пожилом возрасте;
- применение лекарственных препаратов, которые необходимо использовать внутривенно;
- посещение мест с большим скоплением людей (например, салона красоты, больницы, метро).
Лечение
Большинство случаев эндокардита поддаются лечению антибиотиками. В тяжелых случаях их вводят в вену. Исследование культуры крови помогает подобрать правильный антибиотик или их комбинацию. Обычно лечение длится от двух до шести недель.
Хирургическое лечение эндокардита
В 15-25% случаев эндокардит приводит к структурным изменениям в сердце, что требует хирургического лечения.
Операция может потребоваться при:
- сердечной недостаточности, когда сердце недостаточно эффективно перекачивает кровь
- неэффективности лечения антибактериальными либо противогрибковыми средствами
- обнаружении тромбов в полостях сердца
- наличии искусственного клапана
- подозрении на абсцесс или свищ (ненормальное сообщение между полостями) в области сердца.
Для лечения используют три основных типа операций:
- коррекция клапанов с восстановлением их нормальной формы
- замена поврежденных клапанов на искусственные — протезирование
- иссечение абсцесса или удаление свищей.
Как часто возникают стафилококковые инфекции?
Эпидемиологические данные чаще всего относятся к внутрибольничным инфекциям, которые в настоящее время называют инфекциями, связанными со здравоохранением (HCAI). Повышенный риск заражения относится к пациентам после операции (заражение места операции), с ожоговыми ранами, с сосудистыми катетерами, имплантированными протезами, а также проходящим длительную антибактериальную терапию.
Источниками микробов в больнице являются как пациенты, так и персонал, особенно при стафилококковых поражениях кожи или инфекциях, а также хронические носители. Передача в основном происходит через руки персонала. Капельный путь встречается гораздо реже. Такая передача может также происходить от пациентов со стафилококковой пневмонией.
Инфекции Staphylococcus aureus может быть спорадической инфекцией или вспышкой. В случае вспышки необходимо как можно скорее провести эпидемиологическое расследование. Наибольшая угроза эпидемического распространения золотистого стафилококка существует в отделениях неонатологии, интенсивной терапии, хирургии и ожоговых.
Причины эндокардита
Инфекция достигает сердца несколькими путями. Источником заражения могут быть:
- Ротовая полость. Даже обычная чистка зубов с повреждением десен может вызвать попадание бактерий в кровь. Риск увеличивается, если есть хронические заболевания десен или проблемы с зубами (кариес, воспаление внутренних тканей зубов).
- Половые органы. Нелеченные заболевания, передаваемые половым путем — гонорея, хламидиоз — могут способствовать попаданию инфекции в кровоток.
- Медицинские приспособления — шприцы, катетеры, системы для проведения гемодиализа.
У кого повышен риск эндокардита?
Есть группы людей, у которых риск заболеть выше, чем в популяции:
- Пациенты с болезнями клапанного аппарата сердца. Существует две разновидности проблем: клапанный стеноз, при котором есть сужения и нарушения тока крови и клапанная регургитация, при которой клапаны не закрываются должным образом и поток крови движется в неверном направлении. Болезни клапанов могут быть врожденными и приобретенными, т.е. возникшими из-за ревматизма, инфаркта миокарда, гипертонической болезни.
- Люди с протезами клапанов. Риск относительно невысок, только у одного пациента с искусственным клапаном из ста развивается эндокардит.
- Пациенты, страдающие гипертрофической кардиомиопатией. При этой болезни камеры сердца имеют меньший объем за счет утолщения мышечных стенок. Это приводит к снижению потока крови и нарушению расслабления мышц.
- Потребители инъекционных наркотиков, особенно метамфетамина и героина. Инфекция попадает в кровоток после использования нестерильных игл.
- Больные, у которых установлен центральный венозный катетер.
- Люди с иммунодефицитом, например, ВИЧ-инфицированные или получающие химиотерапию.
Острый инфекционный артрит
Острая форма наблюдается в 95% случаев, зафиксированных медиками. В отличие от хронического артрита, который поражает лиц в группе риска, от нее не застрахованы даже абсолютно здоровые люди молодого возраста. Для острого инфекционного артрита — наиболее опасной формы заболевания — характерен сильный отек и жар в области пораженного сустава. Эритрематозные поражения кожи на фоне прочих симптомов — это однозначный повод для вызова “скорой”.
Также немедленно обращаться к врачу нужно, если признаки артрита наблюдаются в течение 2-10 дней после укусов собак, кошек, крыс и других животных, а также человека. Опасны также инфекции пищеварительного тракта. Негонококковый реактивный артрит, который они могут спровоцировать, приводит к разрушению сустава уже в первые часы после начала заболевания!
Гонококковая инфекция, которая передается от матери к ребенку, между половыми партнерами, а также при бытовых контактах, менее опасна. Однако наличие сопутствующих заболеваний (например, ревматоидного артрита или системной красной волчанки) существенно ухудшает клинический прогноз при остром инфекционном артрите.
Лечение ИЭ
1. использовать антимикробные препараты (АМП), активные в отношении потенциальных и установленных возбудителей;
2. применять бактерицидные АМП, так как в вегетациях микро-организмы находятся в состоянии низкой метаболической активности;
3. использовать комбинации АМП, обладающих синергизмом;
4. вводить АМП парентерально для получения более высоких и предсказуемых сывороточных концентраций;
5. антимикробная терапия должна быть длительной для обеспечения стерилизации вегетаций клапанов.
Длительность комбинированной терапии должна составлять не менее 4 нед.,
а для осложнившихся случаев, у пациентов с симптомами на протяжении более 3 мес. и при наличии
протезированного клапана – не менее 6 нед.






























